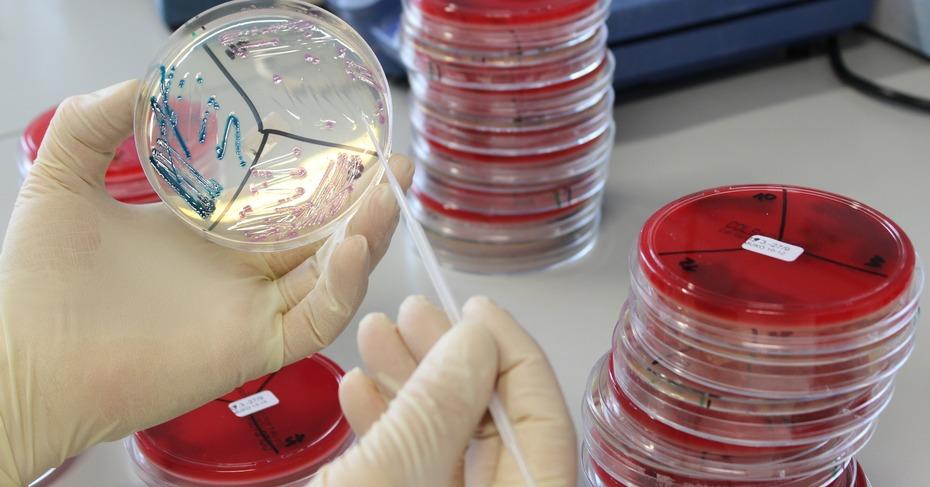
Infectious Disease Molecular Diagnostics Market

The Infectious Disease Molecular Diagnostics Market refers to the segment of the healthcare industry that focuses on the development and use of molecular diagnostic tests for the detection and characterization of infectious diseases. Molecular diagnostics involve the analysis of nucleic acids (DNA or RNA) to identify the genetic material of pathogens, such as bacteria, viruses, fungi, or parasites, in patient samples.
The market for infectious disease molecular diagnostics has experienced significant growth in recent years due to several factors, including the increasing prevalence of infectious diseases, the need for accurate and rapid diagnostic tools, and advancements in molecular biology technologies. These diagnostics play a crucial role in disease diagnosis, treatment decisions, infection control, and surveillance.
Download The Sample Report To Explore The Factors Driving Substantial Growth In The Infectious Disease Molecular Diagnostics Market! Discover Valuable Insights And Trends! https://www.futuremarketinsights.com/reports/sample/rep-gb-15835
In 2021, the market for molecular diagnostics for infectious diseases was estimated to be worth approximately US$ 34 billion. By the end of 2032, the market is anticipated to have grown at a CAGR of 4.2% over the following ten years, with a value of roughly US$ 53 billion. Instead of the conventional approaches that needed the growing of the viruses, developers are increasingly relying on scientific advancements from a range of domains. One of the areas of infectious disease identification that is growing most quickly is molecular diagnostics.
What factors are limiting the Infectious Disease Molecular Diagnostics Market’s expansion?
- Cost and complexity: Molecular diagnostics tests can be expensive to develop, implement, and maintain. The high cost of instruments, reagents, and skilled personnel required for accurate testing can limit the adoption of these technologies, especially in resource-limited settings.
- Regulatory challenges: Molecular diagnostic tests need to comply with regulatory requirements and obtain necessary approvals from regulatory bodies such as the Food and Drug Administration (FDA) in the United States. The stringent regulatory process can be time-consuming and costly, leading to delays in market entry for new tests and technologies.
- Limited accessibility: Molecular diagnostics often require sophisticated laboratory infrastructure and skilled technicians, making them less accessible in remote or underdeveloped areas with limited healthcare resources. This can hinder widespread implementation and use of these tests, particularly in low-income regions.
- Technological complexity: Molecular diagnostics techniques involve complex processes such as nucleic acid amplification and analysis. The need for skilled laboratory personnel and specialized training can act as a barrier to widespread adoption, as not all healthcare facilities may have access to the necessary expertise.
- Competition with alternative diagnostic methods: Molecular diagnostics face competition from other diagnostic methods, such as immunoassays and conventional microbiological culture techniques. These alternative methods may be less expensive, simpler to perform, and more readily available, which can impact the adoption of molecular diagnostics.
It’s important to note that the field of molecular diagnostics is dynamic, and advancements in technology, changes in regulations, and other factors may have influenced the market since my last knowledge update. It’s recommended to consult the latest research and industry reports to get the most up-to-date information on the topic.
Embrace The Future Of Insights With Our Advanced Methodology! https://www.futuremarketinsights.com/request-report-methodology/rep-gb-15835
Infectious Diseases Molecular Diagnostics Market: Competition Analysis
The FMI’s study presents a comprehensive analysis of global, regional, and country-level players active in the Infectious Diseases Molecular Diagnostics market. Competitive information detailed in the Infectious Diseases Molecular Diagnostics market report has been based on innovative product launches, distribution channels, local networks, industrial penetration, production methods, and revenue generation of each market player. Furthermore, growth strategies and mergers & acquisitions (M&A) activities associated with the players are enclosed in the Infectious Diseases Molecular Diagnostics market report.
Key players covered in the report include:
- Abbott
- Danaher Corporation
- bioMérieux SA
- F. Hoffmann-La Roche Ltd
- Bio-Rad Laboratories, Inc.
- Agilent Technologies, Inc.
- Becton, Dickinson, and Company
- Hologic, Inc. (Gen-Probe)
- Illumina, Inc.
- Grifols S.A.
- Qiagen
- Siemens Healthineers AG
- Sysmex Corporation
Infectious Diseases Molecular Diagnostics Market: Segmentation
Valuable information covered in the FMI’s Infectious Diseases Molecular Diagnostics market report has been segregated into key segments and sub-segments.
By Technology:
- Polymerase chain reaction (PCR)
- In Situ Hybridization
- Isothermal Nucleic Acid Amplification Technology (INAAT)
- Chips and Microarrays
- Mass Spectrometry
- Sequencing
- Others
By Product Type:
- Instruments
- Reagents
- Services
By End Use:
- Hospitals
- Clinics
- Diagnostics Laboratories
- Research Institutes
By Application:
- Respiratory Diseases
- Tuberculosis
- Meningitis
- Gastrointestinal Tract Infections
- HPV
- Sexually Transmitted Infections
- Sepsis
- Drug Resistance Diseases
- Other Infectious Diseases
Get Ahead with Detailed Market Intelligence: Purchase Now to Access! https://www.futuremarketinsights.com/checkout/15835
About Future Market Insights (FMI)
Future Market Insights, Inc. (ESOMAR certified, recipient of the Stevie Award, and a member of the Greater New York Chamber of Commerce) offers profound insights into the driving factors that are boosting demand in the market. FMI stands as the leading global provider of market intelligence, advisory services, consulting, and events for the Packaging, Food and Beverage, Consumer Technology, Healthcare, Industrial, and Chemicals markets. With a vast team of over 5000 analysts worldwide, FMI provides global, regional, and local expertise on diverse domains and industry trends across more than 110 countries.
Contact Us:
Future Market Insights Inc.
Christiana Corporate, 200 Continental Drive,
Suite 401, Newark, Delaware – 19713, USA
T: +1-845-579-5705
For Sales Enquiries: sales@futuremarketinsights.com
Website: https://www.futuremarketinsights.com
LinkedIn| Twitter| Blogs | YouTube